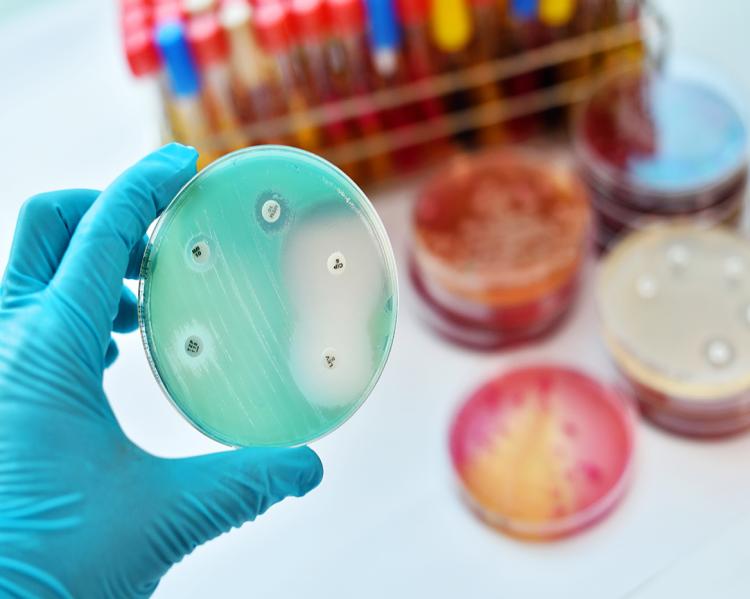

CEE em Pauta
Nossos Conteúdos
- Todos os Assuntos
- Conjuntura Política
- Saúde e sustentabilidade
- SUS, Saúde e Cidadania
- Covid-19 e Doenças emergentes
- Comunicação
- CT&I e Transformação digital
- Saúde mental
- Complexo Econômico-Industrial da Saúde (CEIS)
- Envelhecimento
- Assistência Farmacêutica
- Raça, Gênero e Saúde
- Governança e regulação
- Publicações
- Violência e Saúde
-

-

CT&I e Transformação digital
G20 Saúde aprova por unanimidade declaração ministerial em apoio à saúde global e cooperação internacional
-

SUS, Saúde e Cidadania
Apostas esportivas ou ‘jogos de azar’ como questão de saúde pública, na ‘Lancet’ de novembro
-

CT&I e Transformação digital
No G20, ministra Nísia defende produção regional de insumos de saúde
-

SUS, Saúde e Cidadania
SNT, a joia da saúde pública brasileira
-

SUS, Saúde e Cidadania
9° Fórum Big Data em Oncologia destaca a jornada do câncer em números
-

Envelhecimento
Como a Saúde da Família prolonga a vida de idosos
-

Saúde e sustentabilidade
No Brasil, questão ambiental foi deixada de lado no processo de desenvolvimento agrícola, mostra pesquisa
-

Saúde e sustentabilidade
A Amazônia no Centro do Mundo: COP 30 – 2025
-

Conjuntura Política
Governo Federal destina R$ 4,2 bilhões para alavancar indústria da saúde e atender necessidades do SUS
-
Assistência Farmacêutica
Vacinas poderiam reduzir uso de antibióticos em 2,5 bilhões de doses anualmente, diz OMS
-

Saúde e sustentabilidade
A urgência e os desafios da transição energética justa



